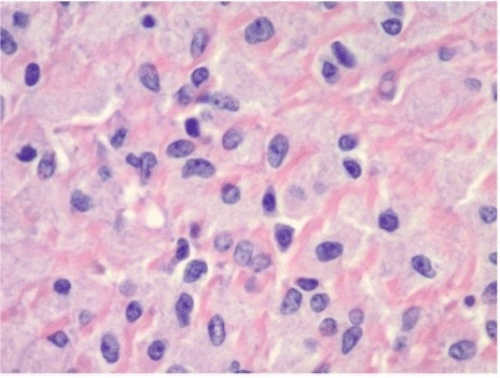
(B) H&E stain, 45x magnification

Disseminated Mycobacterium avium-Intracellular Complex in an HIV Patient with HIV with Massive Splenomegaly
March 6, 2025
Abstract
Background
Disseminated Mycobacterium avium-intracellulare complex (MAC) infection typically occurs in HIV-infected individuals with CD4+ T lymphocyte counts below 50 cells/mm3, manifesting as fever, chills, weight loss, fatigue, diarrhea, and night sweats. Massive splenomegaly in the context of disseminated MAC is a rare finding.
Summary
We present a case of an HIV-positive patient with a CD4+ T lymphocyte count of 10 cells/mm3 exhibiting massive splenomegaly and bulky mesenteric and retroperitoneal lymphadenopathy. Disseminated Mycobacterium avium complex was diagnosed following splenectomy.
Conclusion
The incidence of disseminated MAC has declined significantly due to advances in antiretroviral therapy (ART), though the prognosis remains poor. In HIV-infected patients with CD4+ counts below 50 cells/mm3 presenting with massive splenomegaly and bulky intra-abdominal lymphadenopathy, disseminated MAC should be strongly considered. Confirmation of the diagnosis requires a positive culture, which can be challenging due to the prolonged culture time. While treatment may involve CT-guided aspiration of mesenteric or retroperitoneal lymph nodes, splenectomy should be considered for both diagnostic and therapeutic purposes when aspiration is not feasible.
Key Words
HIV; splenomegaly; Mycobacterium avium-intracellulare complex
Abbreviations
human immunodeficiency virus (HIV-1)
Mycobacterium avium-intracellulare complex (MAC)
Pneumocystis pneumonia (PCP)
antiretroviral therapy (ART)
Grocott's methenamine silver (GMS)
Periodic acid-Schiff (PAS)
Case Description
A 37-year-old Caucasian female with known HIV-1 presented to the emergency room with a one-week history of shortness of breath, bilateral lower extremity edema, abdominal fullness, nausea, vomiting, and a 30-pound weight loss. She reported non-compliance with her prescribed HIV medication, Biktarvy. On examination, she was afebrile, pale, and cachectic, with a BMI of 16. Physical exam revealed a distended abdomen and palpable hepatosplenomegaly. Laboratory studies were notable for pancytopenia (hemoglobin 5.2 g/dL, white blood cell count 2.6 × 103/mm3), hypoalbuminemia (2.3 g/dL), and a CD4+ T lymphocyte count of 10 cells/mm3.
A CT scan of the abdomen (Figure 1) demonstrated marked hepatosplenomegaly (spleen measuring 23 × 15 × 9 cm) and retroperitoneal and mesenteric lymphadenopathy. The differential diagnosis included metastatic lymphoma, disseminated Mycobacterium avium-intracellulare complex (MAC), Castleman disease, and tuberculosis. The patient was started on PCP prophylaxis (atovaquone) and broad-spectrum antibiotics (vancomycin and cefepime). Cardiology was consulted, and a transthoracic echocardiogram showed no acute abnormalities. A multidisciplinary team (hematology/oncology, infectious disease, internal medicine, and general surgery) recommended splenectomy for both diagnostic and therapeutic purposes.
Figure 1. Abdominal and Pelvic CT Imaging with IV Contrast. Published with Permission
A.

B.

C.

Pre-splenectomy vaccinations were deferred due to the low CD4+ count. The splenic artery was embolized by interventional radiology, and an open splenectomy was performed. The open approach was favored due to the concern for malignancy, the patient's body habitus, and the massive splenomegaly. Postoperatively, infectious disease recommended continuing atovaquone and resuming Biktarvy. Blood cultures obtained on admission subsequently grew Mycobacterium avium complex approximately three weeks later.
Pathology revealed a spleen measuring 26.0 × 17.0 × 11.5 cm and weighing 2201 grams. Ziehl-Neelsen staining demonstrated macrophages engorged with acid-fast organisms (Figure 2). Grocott methenamine silver (GMS) and periodic acid-Schiff (PAS) stains were negative. Given the positive acid-fast bacilli, disseminated MAC was presumed, and the patient was started on azithromycin, rifabutin, and ethambutol. The patient was discharged with a plan for post-splenectomy vaccinations in clinic.
Figure 2. Histopathological Analysis. Published with Permission
A.

B.
C.

Discussion
Disseminated Mycobacterium avium-intracellulare complex (MAC) infection occurs in HIV-infected patients with CD4+ T lymphocyte counts below 50 cells/mm3. In the pre-HAART era, the reported incidence of disseminated MAC in patients with advanced immunosuppression ranged from 20% to 40%,1,2 but has significantly decreased with advances in ART. Disseminated MAC typically presents with fever, weight loss, fatigue, diarrhea, night sweats, abdominal pain, anemia, and elevated alkaline phosphatase.3 Massive splenomegaly as a manifestation of disseminated MAC in HIV-infected individuals is rare, with only a few cases reported in the literature through retrospective reviews,4 imaging analysis,5 and individual case presentations.6‒8 The criterion for massive splenomegaly is enlargement of the spleen measured by size or weight. The European Association for Endoscopic Surgery defines massive splenomegaly based on preoperative imaging, with a maximum splenic diameter exceeding 20 cm.9,10 Alternatively, a weight criterion can also be used, defining massive splenomegaly as a spleen weighing more than 1000 g.
CT findings in disseminated MAC often include marked hepatomegaly, splenomegaly, multiple intra-abdominal lymph nodes larger than 10mm in diameter, and jejunal wall thickening.5 Nyberg et al. reported that 84% of patients with disseminated MAC have CT findings of large, bulky retroperitoneal and mesenteric lymphadenopathy, with often normally-sized peripheral lymph nodes.11 Our patient's CT scan demonstrated both hepatosplenomegaly and mesenteric and retroperitoneal lymphadenopathy. Furthermore, a significant proportion of patients with disseminated MAC have a history of at least one prior AIDS-defining illness, such as Kaposi sarcoma, lymphoma, Pneumocystis carinii pneumonia, cytomegalovirus infection, esophageal candidiasis, toxoplasmosis, or cryptosporidiosis.5
Treatment of disseminated MAC requires a positive culture for appropriate antibiotic selection, but obtaining cultures can be challenging due to the prolonged time required for mycobacterial growth. Nyberg et al. recommend CT-guided percutaneous needle aspiration of intra-abdominal lymph nodes as a method to obtain tissue for diagnosis of MAC.11 Due to the rarity of massive splenomegaly in disseminated MAC, there is no established surgical consensus. In our case, a multidisciplinary approach guided the decision for open splenectomy, considering factors such as spleen size, preoperative malnutrition, and low body mass index. Laparoscopic splenectomy for massive splenomegaly has been associated with increased morbidity, longer postoperative stays, higher conversion rates, and a substantially greater risk of postoperative complications compared to open splenectomy.12,13
Diagnosing MAC infection relies on culturing the organism from a normally sterile body site. While cultures from any such site can be diagnostic, blood, bone marrow, lymph nodes, and liver are the most commonly involved tissues and, thus, the preferred samples for culture.14 The histopathological findings in this case are consistent with disseminated MAC infection. The presence of poorly defined granulomas with pale blue, striated histiocytes harboring mycobacteria is characteristic of this disease.15 While Klatt et al. describe necrotic areas filled with inflammatory cells and nuclear debris as a potential histological feature of disseminated MAC, the observed findings, in this case, support a diagnosis nonetheless.15
In patients presenting with massive splenomegaly, disseminated MAC should be a high consideration in the differential diagnosis. Due to the critical need for a definitive diagnosis to guide potentially life-saving treatment and the often lengthy turnaround time for positive cultures, a combined diagnostic and therapeutic splenectomy should be strongly considered in this setting to obtain tissue for definitive diagnosis of MAC, allowing for the prompt initiation of appropriate targeted therapy.
Conclusion
Disseminated MAC infection has become increasingly rare due to advances in antiretroviral therapy (ART). However, in HIV-infected patients with CD4+ counts below 50 cells/mm3 presenting with massive splenomegaly and bulky intra-abdominal lymphadenopathy, disseminated MAC should remain a diagnostic consideration. A positive culture is required for definitive diagnosis and targeted treatment. The prolonged time required for culture growth can pose a diagnostic challenge. Treatment strategies include CT-guided aspiration of mesenteric or retroperitoneal lymph nodes. When CT-guided aspiration is not feasible, splenectomy should be considered for both diagnostic and therapeutic purposes.
Lessons Learned
Disseminated MAC should be included in the differential diagnosis for patients presenting with massive splenomegaly, particularly in the context of advanced HIV infection. Given the poor prognosis associated with disseminated MAC, prompt diagnosis and treatment are crucial. While a positive culture is the gold standard for diagnosis, treatment should not be delayed solely due to the time required for culture growth.
Therefore, in cases of massive splenomegaly where less invasive diagnostic methods are inconclusive or unavailable, diagnostic and therapeutic splenectomy should be strongly considered to obtain tissue for analysis and expedite the initiation of appropriate therapy.
In patients exhibiting resistance or non-compliance with HIV treatment, a broader differential diagnosis, including other opportunistic infections and potential lymphomas, must be considered alongside disseminated MAC. This underscores the importance of a comprehensive diagnostic approach and emphasizes the need for patient adherence to ART for optimal management and improved outcomes.
Authors
Daily ABa; Miguez MWb; Raza Ac
Author Affiliations
- Department of General Surgery, Willis-Knighton Health System, Shreveport, LA 71103
- Department of Pathology, Rapides Regional Medical Center, Alexandria, LA 71301
- Department of Colorectal Surgery, Rapides Regional Medical Center, Alexandria, LA 71301
Corresponding Author
Ahsan Raza, MD, FACS, FASCRS
Department of Colorectal Surgery
Rapides Regional Medical Center
211 North 4th Street
Alexandria, LA 71301
Email: ahsan.raza@hcahealthcare.com
Disclosure Statement
The authors have no conflicts of interest to disclose.
Funding/Support
The authors have no relevant financial relationships or in-kind support to disclose.
Received: December 19, 2022
Revision received: April 10, 2023
Accepted: June 27, 2023
References
- Nightingale SD, Byrd LT, Southern PM, Jockusch JD, Cal SX, Wynne BA. Incidence of Mycobacterium avium-intracellulare complex bacteremia in human immunodeficiency virus-positive patients. J Infect Dis. 1992;165(6):1082-1085. doi:10.1093/infdis/165.6.1082
- Chaisson RE, Moore RD, Richman DD, Keruly J, Creagh T. Incidence and natural history of Mycobacterium avium-complex infections in patients with advanced human immunodeficiency virus disease treated with zidovudine. The Zidovudine Epidemiology Study Group. Am Rev Respir Dis. 1992;146(2):285-289. doi:10.1164/ajrccm/146.2.285
- Gordin FM, Cohn DL, Sullam PM, Schoenfelder JR, Wynne BA, Horsburgh CR Jr. Early manifestations of disseminated Mycobacterium avium complex disease: a prospective evaluation. J Infect Dis. 1997;176(1):126-132. doi:10.1086/514014
- O'Reilly RA. Splenomegaly in 2,505 patients at a large university medical center from 1913 to 1995. 1963 to 1995: 449 patients. West J Med. 1998;169(2):88-97.
- Radin DR. Intraabdominal Mycobacterium tuberculosis vs Mycobacterium avium-intracellulare infections in patients with AIDS: distinction based on CT findings. AJR Am J Roentgenol. 1991;156(3):487-491. doi:10.2214/ajr.156.3.1899742
- Olmedo-Reneaum A, Molina-Jaimes A, Conde-Vazquez E, Montero-Vazquez S. Rosai-Dorfman disease and superinfection due to Salmonella enterica and Mycobacterium avium complex in a patient living with HIV. IDCases. 2020;19:e00698. Published 2020 Jan 14. doi:10.1016/j.idcr.2020.e00698
- Massoth LR, Louissaint A Jr. Massive Splenomegaly from Disseminated Mycobacterium avium-intracellulare Infection. N Engl J Med. 2020;382(11):1041. doi:10.1056/NEJMicm1905550
- Hagiwara T, Amano K, Sugimura D, et al. Massive and progressive hepatosplenomegaly caused by disseminated nontuberculous mycobacteriosis in a patient with acquired immunodeficiency syndrome. Kekkaku (Tuberculosis). 1990;70(7):423-429.
- Sun X, Liu Z, Selim MH, Huang Y. Hand-assisted Laparoscopic Splenectomy Advantages Over Complete Laparoscopic Splenectomy For Splenomegaly. Surg Laparosc Endosc Percutan Tech. 2019;29(2):109-112. doi:10.1097/SLE.0000000000000640
- Tao HS, Lin JY, Luo W, et al. Application of Real-Time Augmented Reality Laparoscopic Navigation in Splenectomy for Massive Splenomegaly. World J Surg. 2021;45(7):2108-2115. doi:10.1007/s00268-021-06082-8
- Nyberg DA, Federle MP, Jeffrey RB, Bottles K, Wofsy CB. Abdominal CT findings of disseminated Mycobacterium avium-intracellulare in AIDS. AJR Am J Roentgenol. 1985;145(2):297-299. doi:10.2214/ajr.145.2.297
- Pozo AL, Godfrey EM, Bowles KM. Splenomegaly: investigation, diagnosis and management. Blood Rev. 2009;23(3):105-111. doi:10.1016/j.blre.2008.10.001
- Patel AG, Parker JE, Wallwork B, et al. Massive splenomegaly is associated with significant morbidity after laparoscopic splenectomy. Ann Surg. 2003;238(2):235-240. doi:10.1097/01.sla.0000080826.97026.d8
- Riddell J 4th, Kaul DR, Karakousis PC, Gallant JE, Mitty J, Kazanjian PH. Mycobacterium avium complex immune reconstitution inflammatory syndrome: long term outcomes. J Transl Med. 2007;5:50. Published 2007 Oct 15. doi:10.1186/1479-5876-5-50
- Klatt EC, Jensen DF, Meyer PR. Pathology of Mycobacterium avium-intracellulare infection in acquired immunodeficiency syndrome. Hum Pathol. 1987;18(7):709-714. doi:10.1016/s0046-8177(87)80242-3